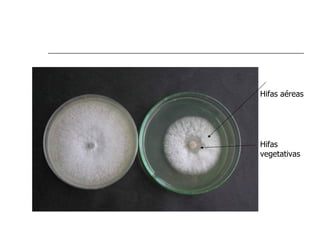
Hifas aéreas




Hifas
vegetativas

1. O documento discute a herança extranuclear em fungos e leveduras, especificamente seu genoma mitocondrial.
2. Fungos podem se reproduzir de forma assexuada através de esporos ou sexualmente. Leveduras se reproduzem principalmente por brotamento.
3. Experimentos com mutantes de Neurospora e cruzamentos de leveduras demonstraram que genes mitocondriais são transmitidos apenas pela linhagem materna, indicando herança extranuclear.

![Class Genome Size Acc. # Code Total Basic Other ORFs rRNAs Reference
Organism
/Structure /Update ORFs 14 /tRNAs
Allomyces macrogynus Chy 57,473 NC001715 U 27 all rps3 2 Paquin and Lang
1996
C 3/96 25
Aspergillus nidulans Asc-F 33,300 FMGP S ~17 all rps3 2 Brown et al. 1985
C rnpB ~22
Candida albicans Asc-Y 40,420 NC002653 Y 12 all 2 Anderson et al. 2001
C 1/01 30
Harpochytrium #94 Mon 19,473 FMGP U 14 all 2* FMGP
C 8#
Harpochytrium #105 Mon 24,570 FMGP U 14 all 2* FMGP
C 8#
Hyaloraphidium curvatum Chy 29,593 NC003048 S 18 all 2* Forget et al. 2002
L 8/01 7#
Hypocrea jeorina Asc-F 42,130 NC003388 S 19 all rps3 2 Chambergo et al.
2002
(Trichoderma reesei) C 2/02 26
Neurospora crassa Asc-F 64,840 Whitehead S ~30 all rps3 2 Griffiths et al.1995
Institute
C 27
Pichia canadensis Asc-Y 27,694 NC001762 S 17 all rps3 2 Sekito et al. 1995
(Hansenula wingei) C 9/95 25
Podospora anserina Asc-F 100,300 NC001329 S 50 -atp9 rps3 2 Cummings et al.
1990
C 1/01 27
Rhizopus stolonifer Zyg 54,178 FMGP U 19 all rnpB 2 FMGP
C 24
[a] Asc = Ascomycete (Y = yeast or non-filamentous, F = filamentous), Bas = Basidiomycete, Chy = Chytridiomycete, Mon = Monoblepharidales, Zyg =
Zygomycete
[b] Genome size in bp; C = circular, L = linear
[c] NCBI accession number or source of information
[d] Genetic code: U = universal; S= standard mitochondria with UGA coding for Trp, rather than termination; Y= yeast codon usage, with AUA coding for
Met, not Ile, CUN = Thr, not Leu, and UGA is Trp, not Ter; C = Chlorophycean mitochondrial code with UAG being Leu, not Ter
[e] Known polypeptides and ORFs greater than 100 amino acids
[f] Fourteen genes common to most fungal mtDNAs; cob, cox1, cox2, cox3, nad1, nad2, nad3, nad4, nad4L, nad5, nad6, atp6, atp8, atp9. Minus signs
indicate the absence of the gene indicated
[g] Additional known genes: rps3 = small ribosomal protein subunit 3 (also includes small ribosomal protein S5 and Var1); rnpB = RNA component of
RNase P. Intron-encoded proteins are excluded
[h] Indicates number of rRNA genes (those with asterisk are split) and tRNA genes (those with # contain members that are edited)
[i] FMGP = Fungal Mitochondrial Genome Project (http://megasun.bch.umontreal.ca/People/lang/FMGP/seqprojects.html)
[j] 86% sequenced](https://image.slidesharecdn.com/heranaextranuclearemfungos-120606184137-phpapp02/85/Heranca-extranuclear-em-fungos-35-320.jpg)
